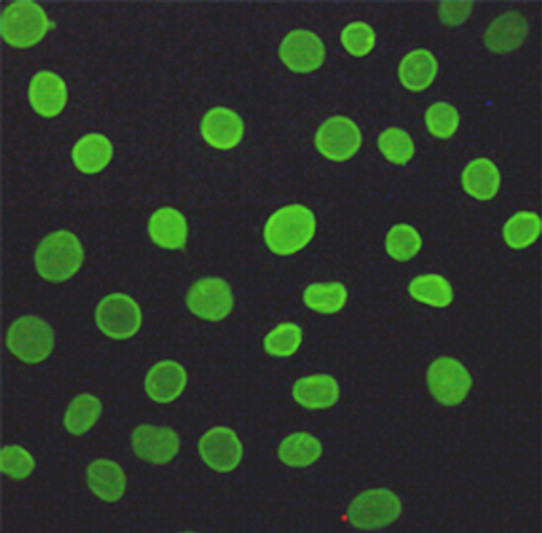
Immunofluorescent analysis of A549 cells fixed with 4% Paraformaldehyde and using anti-Lamin A/C mouse mAb (dilution 1:200).

Anti-LMNA antibody [5D12-C6-E9] (STJ99233)
SPECIFICATIONS
ClonalityMonoclonal
HostMouse
ConjugationUnconjugated
IsotypeIgG1
ImmunogenPurified recombinant human LMNA protein fragments expressed in E.coli.
General Information
| Short Description | Mouse monoclonal anti-Prelamin-A/C for use in WB and IF in Human samples. Datasheet included with dilution recommendations, and related reagents. |
| Applications | WB/IF |
| Host | Mouse |
| Reactivity | Human |
| Note | STRICTLY FOR FURTHER SCIENTIFIC RESEARCH USE ONLY (RUO). MUST NOT TO BE USED IN DIAGNOSTIC OR THERAPEUTIC APPLICATIONS. |
Product Properties
| Clonality | Monoclonal |
| Clone ID | 5D12-C6-E9 |
| Isotype | IgG1 |
| Conjugation | Unconjugated |
| Concentration | 1 mg/mL |
| Purification | The antibody was affinity-purified from mouse ascites by affinity-chromatography using epitope-specific immunogen. |
| Dilution Range | WB 1:1000ICC 1:200IF 1:50-200 |
| Formulation | Liquid in PBS containing 50% Glycerol, 0.5% BSA and 0.02% Sodium Azide. |
| Storage Instruction | Store at-20°C for up to 1 year from the date of receipt, and avoid repeat freeze-thaw cycles. |
Target Information
| Gene Symbol | LMNA |
| Gene ID | 4000 |
| Uniprot ID | LMNA_HUMAN |
| Immunogen | Purified recombinant human LMNA protein fragments expressed in E.coli. |
| Specificity | This antibody detects endogenous levels of Lamin A/C and does not cross-react with related proteins. |
Additional Info
| Post Translational Modifications | Proteolytic cleavage of the C-terminal of 18 residues of prelamin-A/C results in the production of lamin-A/C. The prelamin-A/C maturation pathway includes farnesylation of CAAX motif by protein farnesyltransferase (FNTA and FNTB), removal of the last three amino acids (-AAX) by RCE1/FACE2 and/or ZMPSTE24, methylation of the C-terminal cysteine by ICMT and endoproteolytic removal of the last 15 C-terminal amino acids by ZMPSTE24. Proteolytic cleavage requires prior farnesylation and methylation, and absence of these blocks cleavage. Farnesylation of prelamin-A/C facilitates nuclear envelope targeting. Phosphorylation plays a key role in lamin organization, subcellular localization and nuclear envelope disintegration. Phosphorylation by CDK1 at Ser-22 and Ser-392 at the onset of mitosis drives lamin disassembly and nuclear envelope breakdown. Phosphorylation at Ser-22 and Ser-392 during interphase promotes localization to the nucleoplasm and regulates lamina assembly. Phosphorylation at Ser-22, Ser-392 and Ser-628 during interphase causes redistribution between the nucleus and the cytoplasm. Phosphorylation at Ser-22 by CDK1 regulates matrix stiffness. Phosphorylation status of Ser-22 determines its localization between double-strand break (DSB) sites and the nuclear matrix. Phosphorylated by ATR at Ser-282 in response to DNA damage, leading to lamin disassembly and nuclear envelope rupture. Phosphorylation also regulates stability in micronuclei arising from genome instability: phosphorylation at Ser-395 by ATR in response to genome instability and double-stranded DNA breaks primes LMNA for subsequent phosphorylation at Ser-392 by CDK1 and micronuclei envelope rupture. The rupture of micronuclear envelope triggers the cGAS-STING pathway thereby activating the type I interferon response and innate immunity. Acetylation by KAT8 is required for nuclear architecture. Sumoylation is necessary for the localization to the nuclear envelope. |
| Function | Lamin-A/C: Lamins are intermediate filament proteins that assemble into a filamentous meshwork, and which constitute the major components of the nuclear lamina, a fibrous layer on the nucleoplasmic side of the inner nuclear membrane. Lamins provide a framework for the nuclear envelope, bridging the nuclear envelope and chromatin, thereby playing an important role in nuclear assembly, chromatin organization, nuclear membrane and telomere dynamics. Lamin A and C also regulate matrix stiffness by conferring nuclear mechanical properties. The structural integrity of the lamina is strictly controlled by the cell cycle, as seen by the disintegration and formation of the nuclear envelope in prophase and telophase, respectively. Lamin A and C are present in equal amounts in the lamina of mammals. Also invoved in DNA repair: recruited by DNA repair proteins XRCC4 and IFFO1 to the DNA double-strand breaks (DSBs) to prevent chromosome translocation by immobilizing broken DNA ends. Required for normal development of peripheral nervous system and skeletal muscle and for muscle satellite cell proliferation. Required for osteoblastogenesis and bone formation. Also prevents fat infiltration of muscle and bone marrow, helping to maintain the volume and strength of skeletal muscle and bone. Required for cardiac homeostasis. Prelamin-A/C: Prelamin-A/C can accelerate smooth muscle cell senescence. It acts to disrupt mitosis and induce DNA damage in vascular smooth muscle cells (VSMCs), leading to mitotic failure, genomic instability, and premature senescence. |
| Protein Name | Prelamin-A/C Cleaved Into - Lamin-A/C70 Kda LaminRenal Carcinoma Antigen Ny-Ren-32 |
| Database Links | Reactome: R-HSA-1221632 P02545-2Reactome: R-HSA-2980766Reactome: R-HSA-2995383Reactome: R-HSA-352238 P02545-1Reactome: R-HSA-381038Reactome: R-HSA-4419969Reactome: R-HSA-6802952Reactome: R-HSA-8862803 P02545-1 |
| Cellular Localisation | Nucleus LaminaNucleus EnvelopeNucleusNucleoplasmNucleus MatrixFarnesylation Of Prelamin-A/C Facilitates Nuclear Envelope Targeting And Subsequent Cleavage By Zmpste24/Face1 To Remove The Farnesyl Group Produces Mature Lamin-A/CWhich Can Then Be Inserted Into The Nuclear LaminaEmd Is Required For Proper Localization Of Non-Farnesylated Prelamin-A/CAlso Localizes To The Micronuclear Envelope In Response To Response To Genome InstabilityIsoform C: Nucleus Speckle |
| Alternative Antibody Names | Anti-Prelamin-A/C Cleaved Into - Lamin-A/C antibodyAnti-70 Kda Lamin antibodyAnti-Renal Carcinoma Antigen Ny-Ren-32 antibodyAnti-LMNA antibodyAnti-LMN1 antibody |
Information sourced from Uniprot.org